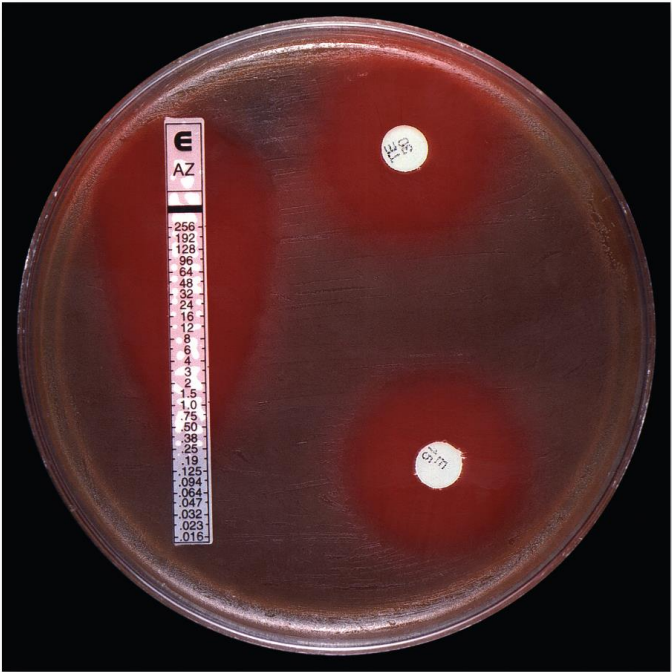
<p>Etest</p>

BIO 120 Lecture Exam 3
1/26
There's no tags or description
Looks like no tags are added yet.
Name | Mastery | Learn | Test | Matching | Spaced | Call with Kai |
|---|
No analytics yet
Send a link to your students to track their progress
27 Terms
Goal of Antimicrobial Chemotherapy
administer a drug to an infected person that destroys the infective agent without harming the host’s cells
Characteristics of Ideal Antimicrobial Drug
Toxic to the microbe, but nontoxic to the host
Does not lead to development of antimicrobial resistance
Microbiocidal rather than microbiostatic
Complements or assists the activities of the host’s defenses
Reasonably priced
Relatively soluble; functions even when highly diluted in body fluids
Remains active in tissues and body fluids
Does not disrupt the host’s health by causing allergies or predisposing the host to other infections
Remains potent long enough to act and is not broken down or excreted prematurely
Readily delivered to the site of infection
Prophylaxis
use of a drug to prevent imminent infection of a person at risk
Antimicrobial Chemotherapy
the use of drugs to control infection
Antimicrobials
all-inclusive term for any antimicrobial drug, regardless of what type of microorganism it targets
Antibiotics
substances produced by the natural metabolic processes of some microorganisms - or created by scientists - that can inhibit or destroy microorganisms; generally, the term is used for drugs targeting bacteria and not other types of microbes.
Semisynthetic Drugs
drugs that are chemically modified in the lab after being isolated from natural sources
Synthetic Drugs
drugs produced entirely by chemical reactions within a lab setting
Narrow-Spectrum (limited spectrum)
antimicrobials effective against a limited array of microbial types
Broad-Spectrum (extended spectrum)
antimicrobials effective against a wide variety of microbial types
Origins of Antimicrobial Drugs
Antibiotics are common metabolic products of bacteria and fungi
Inhibiting the growth of other microorganisms in the same habitat, reduces competition for nutrients and space
Selective advantage has allowed the genes for antibiotics production to be preserved in evolution
3 Factors to Know Before Starting Antimicrobial Therapy
Identity of the microorganism causing the infection
Degree of the microorganism’s susceptibility (sensitivity) to various drugs
The overall medical condition of the patient
Identifying the Agent
Should be attempted as soon as possible
Before any antimicrobial drug is given
Direct examination of body fluids, sputum, or stool

Kirby-Bauer Technique
Technique for testing for drug susceptibility
The surface of a plate of special medium is spread with the test bacterium
Small discs containing premeasured amounts of antibiotics are dispensed on the bacterial lawn
A zone of inhibition (agar is uncolonized) formed during incubation is measured and compared with a standard for each drug

Etest
An alternative test for drug susceptibility
A strip with different concentrations of a specific antibiotic is placed on a colonized agar plate
Can identify the lowest possible concentration of the antibiotic that the bacteria are susceptible to (MIC)
Minimum Inhibitory Concentration (MIC)
the smallest (highest dilution) of the drug that visibly inhibits growth
Useful in determining the smallest effective dosage of a drug
Provides a comparative index against other antimicrobials
Performed by automated machinery in clinical laboratories
Tube Dilution Test
Used to determine the MIC

MIC and Therapeutic Index
results of antimicrobial sensitivity tests guide the physician’s choice of a suitable drug
Why antimicrobial treatments fail?
Inability of the drug to diffuse into that body compartment (brain, joints, skin, etc)
Resistant microbes in the infection that did not make it into the sample collected for testing
An infection caused by more than one pathogen (mixed), some of which are resistant to the drug
Therapeutic Index (TI)
Ratio of the dose of the drug that is toxic to humans to its minimum effective (therapeutic) dose
The closer these two figures are to one another, the greater the potential for toxic drug reactions
If drugs have similar MICs…
the drug with the highest TI has the widest margin of safety
Patient History
Must be considered, including
Preexisting medical conditions that will influence the activity of the drug or the response of the patient
History of allergy to a certain class of drugs
Underlying liver or kidney disease
Infants, the elderly, and pregnant women require special precautions
Selective Toxicity
Antimicrobial drugs should kill or inhibit microbial cells without simultaneously damaging host tissues
The best drugs in current use block the actions or synthesis of molecules in microorganisms, but not vertebrate cells
Central concept in antibiotic treatment
Difficult to achieve, the more similar the characteristics of the infectious agent become to those of the host
Penicllins
drug that blocks the synthesis of the cell wall found only in bacteria. Exhibits excellent selective toxicity
Drugs that are most toxic to human cells
Act upon a structure common to both the infective agent and the host cell
Metabolic Targets of Chemotherapeutic Agents
Inhibition of cell wall synthesis
Inhibition of nucleic acid (DNA and RNA) structure and function
Inhibition of protein synthesis
Interference with cell membrane structure or function
Inhibition of folic acid synthesis